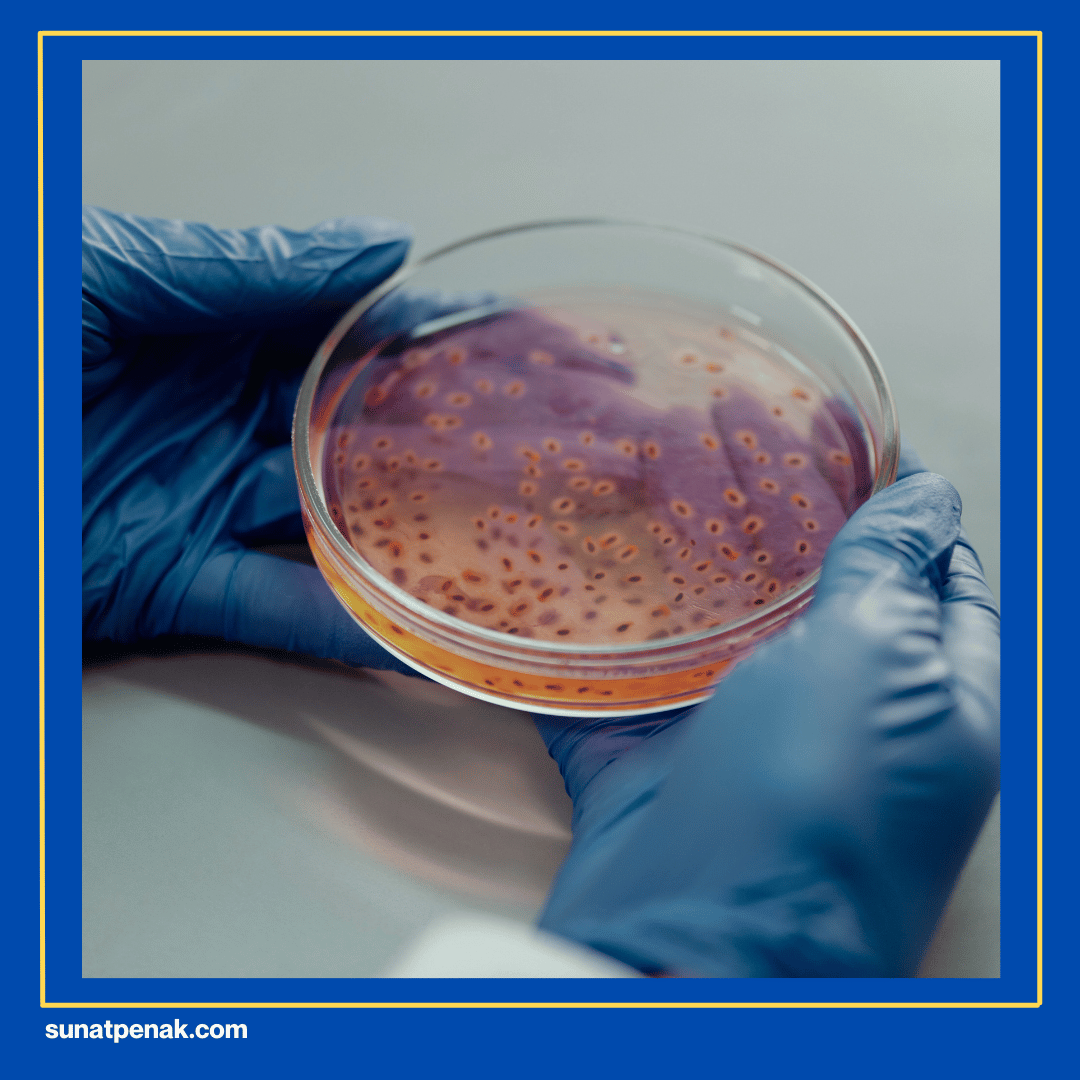
Mengatasi Faktor Penyebab ISK

Sunatpenak.com – Infeksi saluran kemih bukan hanya bisa menyerang wanita saja, Ayah Bunda mungkin tidak menyadari bahwa anak laki-laki pun bisa mengalaminya. Bahkan, dengan frekuensi yang cukup signifikan pada kelompok usia tertentu.
Risiko infeksi saluran kemih pada anak laki-laki belum disunat bisa bisa lebih tinggi dibandingkan yang sudah disunat. Banyak kasus juga menunjukkan bahwa infeksi sering muncul kembali meskipun sudah diberikan pengobatan antibiotik.
Apa hubungannya antara kulit kulup dan kesehatan saluran kemih pada anak laki-laki? Bakteri penyebab infeksi, biasanya Escherichia coli, menumpuk di area kulit kulup yang sulit dibersihkan dengan sempurna.
Kulit kulup yang menutupi kepala penis juga bisa menjadi tempat berkumpulnya kotoran dan cairan yang tidak terlihat, sehingga menjadi media pertumbuhan bakteri yang ideal.
Bahkan ketika anak sudah dibersihkan dengan benar, sisa-sisa kotoran yang tersembunyi masih bisa memicu timbulnya infeksi.
Yuk, Ayah Bunda bahas lebih dalam lagi mengapa sunat bisa menjadi pilihan tepat untuk menjaga kesehatan saluran kemih buah hati berikut ini!
Gejala Infeksi Saluran Kemih
Ayah Bunda perlu memperhatikan tanda-tanda yang muncul pada anak laki-laki, karena gejala infeksi saluran kemih bisa berbeda tergantung usia anak. Pada bayi dan balita di bawah usia dua tahun, biasanya tidak menunjukkan gejala yang jelas terkait saluran kemih.
Mereka hanya tampak rewel, tidak mau makan dengan baik, atau mengalami demam tanpa sebab yang jelas. Kadang juga muncul tanda seperti muntah, diare, atau urine yang berbau tidak sedap dan tampak keruh.
Semnetara, pada anak yang sudah lebih besar, gejalanya menjadi lebih mudah dikenali. Anak akan mengeluh nyeri atau rasa terbakar saat buang air kecil, bahkan sering merasa ingin buang air kecil secara mendadak dan lebih sering dari biasanya.
Urine bisa terlihat keruh, berwarna lebih gelap dari biasanya, atau bahkan mengandung darah sehingga tampak kemerahan. Beberapa anak juga merasakan nyeri di bagian bawah perut atau punggung tepat di bawah tulang rusuk.
Ayah Bunda harus segera membawa anak ke dokter jika menemukan salah satu dari gejala yang tidak wajar, terutama jika sudah berlangsung lebih dari satu hari atau tidak kunjung membaik setelah diberikan perawatan dasar.
Dampak ISK untuk Anak
Infeksi saluran kemih (ISK) bisa memberikan dampak langsung yang mengganggu kondisi anak sehari-hari. Anak akan merasakan ketidaknyamanan seperti nyeri atau rasa terbakar saat buang air kecil, sering ingin buang air kecil secara mendadak, dan urine yang berbau tidak sedap atau tampak keruh.
ISK bisa menyebabkan masalah kesehatan yang lebih serius. Infeksi yang menyebar ke ginjal dapat merusak jaringan organ ini, meningkatkan risiko terbentuknya bekas luka dan gangguan fungsi ginjal jangka panjang.
Anak laki-laki dengan isk juga sering terkait dengan kondisi seperti phimosis, sementara anak perempuan yang mengalaminya saat kecil berisiko menghadapi komplikasi pada masa kehamilan kelak.
ISK juga berdampak pada pertumbuhan dan perkembangan anak secara keseluruhan. Selain itu, rasa tidak nyaman yang berkelanjutan dapat mengganggu konsentrasi anak saat belajar dan berinteraksi dengan teman sebaya.
Manfaat Sunat untuk Isk
Ayah Bunda pasti ingin tahu bagaimana sunat bisa membantu menangani dan mencegah infeksi saluran kemih pada anak. Sunat memberikan manfaat nyata untuk kesehatan saluran kemih, mulai dari mengurangi risiko infeksi hingga menjaga fungsi organ secara optimal. Berikut adalah manfaat utama sunat untuk mengatasi dan mencegah infeksi saluran kemih!
1. Menurunkan Risiko Infeksi Berulang

Sunat menghilangkan kulit kulup yang menjadi tempat berkumpulnya bakteri penyebab ISK, seperti Escherichia coli. Bahkan pada kasus di mana infeksi sudah terjadi berulang kali, sunat bisa menjadi solusi untuk menghentikan siklus infeksi yang mengganggu kesehatan anak.
Manfaat ini tidak hanya berlaku untuk anak-anak, tapi juga memberikan perlindungan jangka panjang hingga dewasa. Bahkan pada anak dengan phimosis, yaitu kulup terlalu ketat, sunat dapat mengatasi masalah tersebut sekaligus mengurangi risiko ISK.
Setelah sunat, area sekitar kepala penis menjadi lebih mudah dibersihkan. Bakteri tidak lagi memiliki tempat untuk berkembang biak, sehingga kemungkinan infeksi kembali menjadi jauh lebih kecil. Anak juga akan merasa lebih nyaman karena tidak perlu lagi khawatir akan rasa sakit atau ketidaknyamanan akibat infeksi yang muncul berulang.
2. Mengatasi Faktor Penyebab ISK
Kulup yang tidak disunat bisa menyebabkan phimosis atau kulit kulup yang terlalu ketat untuk ditarik ke belakang. Kondisi ini tidak hanya menyulitkan pembersihan, namun juga menghambat aliran urine yang lancar.
Urine yang tersisa di saluran kemih kemudian menjadi media pertumbuhan bakteri yang memperparah ISK. Sunat secara langsung mengatasi masalah kulup yang menjadi akar penyebab ISK.
Dengan menghilangkan kulup yang menyumbat, aliran urine menjadi lebih lancar dan tidak ada lagi tempat bagi bakteri untuk menetap. Hal ini membantu tubuh anak dalam membersihkan saluran kemih secara alami setiap kali buang air kecil.
Selain itu, sunat juga mencegah terjadinya infeksi pada kulit penis seperti balanitis yang seringkali menyebar ke saluran kemih. Setelah prosedur sunat, area genital anak jadi lebih mudah dipantau dan dirawat, sehingga Ayah Bunda tidak perlu khawatir akan masalah yang muncul secara tiba-tiba.
3. Mencegah Komplikasi Serius

Tanpa penanganan yang tepat, ISK berulang bisa menyebar ke bagian tubuh lain dan menyebabkan kerusakan yang lebih parah. Tanpa penanganan yang tepat, ISK berulang bisa menyebar ke ginjal dan menyebabkan masalah pada organ penting ini.
Bahkan dalam beberapa kasus, infeksi yang berkepanjangan dapat menyebabkan penyempitan saluran kemih atau gangguan fungsi buang air kecil anak. Sunat membantu mengurangi risiko komplikasi tersebut secara signifikan.
Setelah sunat, anak akan memiliki risiko yang lebih rendah terhadap penyempitan saluran kemih atau kerusakan ginjal akibat infeksi berkepanjangan. Ayah Bunda bisa dengan tenang melihat anak beraktivitas tanpa harus khawatir akan masalah kesehatan yang muncul secara tiba-tiba.
BACA JUGA : Penyebab Kulup Bisa Bengkak
Layanan Sunat Anak yang Aman
Layanan sunat anak yang aman menjadi prioritas utama bagi setiap orang tua yang ingin menjaga kesehatan buah hati. Di Sunatpenak, klinik Asy-Syifa Ngadirojo Wonogiri kami menyediakan proses sunat yang khusus untuk membuat anak merasa nyaman dan aman selama dan setelah prosedur.
Proses sunat dilakukan oleh tenaga medis berpengalaman dan terlatih secara profesional, dengan menerapkan standar kebersihan dan sterilisasi yang ketat. Setiap alat yang digunakan sudah melalui proses sterilisasi untuk menghindari risiko infeksi selama prosedur.
Sebelum melakukan prosedur, tim Sunatpenak melakukan konsultasi mendalam dengan Ayah Bunda, menjelaskan setiap tahapan dengan jelas dan menjawab semua kekhawatiran yang ada.
Ayah Bunda juga akan mendapatkan panduan perawatan pasca-sunat yang mudah diikuti, termasuk cara membersihkan luka, tanda-tanda yang perlu diwaspadai, dan jadwal kontrol. Informasi lebih lanjut atau konsultasi gratis, kunjungi website resmi Sunatpenak, atau hubungi kami di bawah ini!
Website Resmi : sunatpenak.com
Alamat : Klinik Asy-syifa Ngadirojo Wonogiri Manggis, 1 No.11, Manggis, Ngadirojo Kidul, Kec. Ngadirojo, Kabupaten Wonogiri, Jawa Tengah 57681
Whatsapp : +6281 2264 1127


